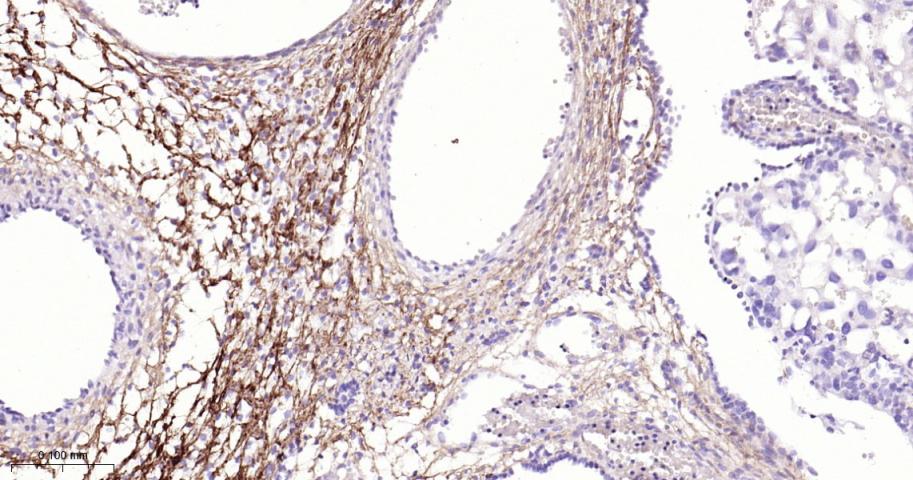
角膜上皮蛋白TGFBI重组兔单抗
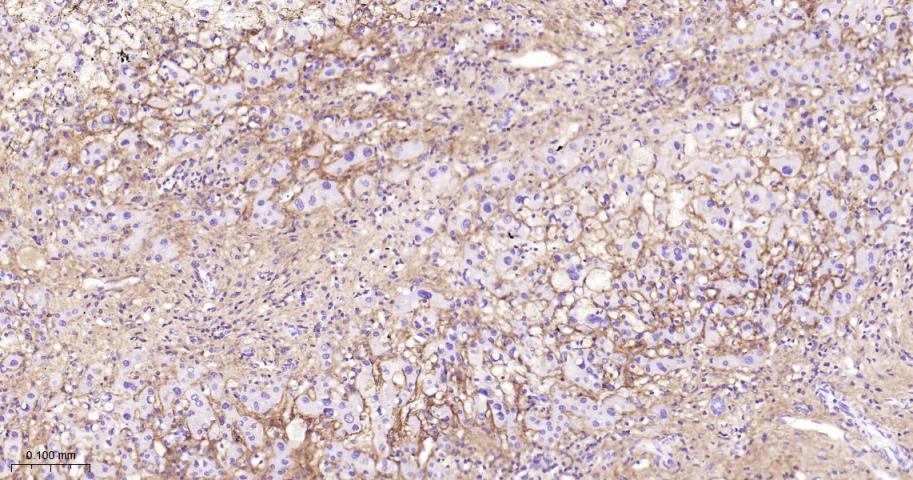
角膜上皮蛋白TGFBI重组兔单抗

角膜上皮蛋白TGFBI重组兔单抗
Rrmab?兔单抗

货号:bsm-54085R
产品详情
相关标记
相关产品
相关文献
常见问题
概述
产品编号
bsm-54085R
产品类型
重组兔单抗
英文名称
TGFBI Recombinant Rabbit mAb
中文名称
角膜上皮蛋白TGFBI重组兔单抗
英文别名
BIGH3; CDB1; CDG2; CDGG1; CSD; CSD1; CSD2; CSD3; EBMD; LCD1; 68kDa; Beta-ig; big-h3; BGH3_HUMAN; TGFBI; Beta ig-h3; Kerato-epithelin; RGD-containing collagen-associated protein (RGD-CAP); BGH3_MOUSE;
抗体来源
Rabbit
免疫原
A synthesized peptide derived from human TGFBI: 100-150
亚型
IgG
性状
Liquid
纯化方法
affinity purified by Protein A
克隆类型
Recombinant
克隆号
9C2
理论分子量
72 kDa
浓度
1mg/ml
储存液
0.01M TBS (pH7.4) with 1% BSA, 0.02% Proclin300 and 50% Glycerol.
研究领域
Developmental Biology > Organogenesis > Excretory system development > Kidney development
Neuroscience > Sensory System > Visual system
Signal Transduction > Cytoskeleton / ECM > Extracellular Matrix > ECM Proteins > Collagen
Signal Transduction > Cytoskeleton / ECM > Extracellular Matrix > ECM Proteins > Other ECM Proteins
Signal Transduction > Cytoskeleton / ECM > Extracellular Matrix > Structures > Bone
SWISS
Gene ID
保存条件
Shipped at 4℃. Store at -20℃ for one year. Avoid repeated freeze/thaw cycles.
注意事项
This product as supplied is intended for research use only, not for use in human, therapeutic or diagnostic applications.
数据库链接
背景资料
This gene encodes an RGD-containing protein that binds to type I, II and IV collagens. The RGD motif is found in many extracellular matrix proteins modulating cell adhesion and serves as a ligand recognition sequence for several integrins. This protein plays a role in cell-collagen interactions and may be involved in endochondrial bone formation in cartilage. The protein is induced by transforming growth factor-beta and acts to inhibit cell adhesion. Mutations in this gene are associated with multiple types of corneal dystrophy. [provided by RefSeq, Jul 2008]

产品应用
| 应用 | 已检合格种属 | 预测种属 | 推荐稀释比例 |
|---|---|---|---|
| WB | Mouse, Rat | Human | 1:500-2000 |
| IHC-P | Human, Mouse, Rat | 1:50-200 | |
| IHC-F | Human, Mouse, Rat | 1:50-200 | |
| IF | Human, Mouse, Rat | 1:50-200 | |
| Flow-Cyt | Human | Mouse, Rat | 1:50-100 |
交叉反应
交叉反应: Human, Mouse, Rat
相关产品
暂无相关产品
靶标
基因名
TGFBI
蛋白名
Transforming growth factor-beta-induced protein ig-h3
亚细胞定位
Secreted > extracellular space > extracellular matrix. May be associated both with microfibrils and with the cell surface.
Tissue Specificity : Highly expressed in the corneal epithelium.
组织特异性
Highly expressed in the corneal epithelium.
翻译后修饰
Gamma-carboxyglutamate residues are formed by vitamin K dependent carboxylation. These residues are essential for the binding of calcium.
疾病
Defects in TGFBI are the cause of epithelial basement membrane corneal dystrophy (EBMD) [MIM:121820]; also known as Cogan corneal dystrophy or map-dot-fingerprint type corneal dystrophy. EBMD is a bilateral anterior corneal dystrophy characterized by grayish epithelial fingerprint lines, geographic map-like lines, and dots (or microcysts) on slit-lamp examination. Pathologic studies show abnormal, redundant basement membrane and intraepithelial lacunae filled with cellular debris. Although this disorder usually is not considered to be inherited, families with autosomal dominant inheritance have been identified.
Defects in TGFBI are the cause of corneal dystrophy Groenouw type 1 (CDGG1) [MIM:121900]; also known as corneal dystrophy granular type. Inheritance is autosomal dominant. Corneal dystrophies show progressive opacification of the cornea leading to severe visual handicap.
Defects in TGFBI are the cause of corneal dystrophy lattice type 1 (CDL1) [MIM:122200]. Inheritance is autosomal dominant.
Defects in TGFBI are a cause of corneal dystrophy Thiel-Behnke type (CDTB) [MIM:602082]; also known as corneal dystrophy of Bowman layer type 2 (CDB2). Defects in TGFBI are the cause of Reis-Buecklers corneal dystrophy (CDRB) [MIM:608470]; also known as corneal dystrophy of Bowman layer type 1 (CDB1). Defects in TGFBI are the cause of lattice corneal dystrophy type 3A (CDL3A) [MIM:608471]. CDL3A clinically resembles to lattice corneal dystrophy type 3, but differs in that its age of onset is 70 to 90 years. It has an autosomal dominant inheritance pattern.
Defects in TGFBI are the cause of Avellino corneal dystrophy (ACD) [MIM:607541]. ACD could be considered a variant of granular dystrophy with a significant amyloidogenic tendency. Inheritance is autosomal dominant.
Defects in TGFBI are the cause of corneal dystrophy Groenouw type 1 (CDGG1) [MIM:121900]; also known as corneal dystrophy granular type. Inheritance is autosomal dominant. Corneal dystrophies show progressive opacification of the cornea leading to severe visual handicap.
Defects in TGFBI are the cause of corneal dystrophy lattice type 1 (CDL1) [MIM:122200]. Inheritance is autosomal dominant.
Defects in TGFBI are a cause of corneal dystrophy Thiel-Behnke type (CDTB) [MIM:602082]; also known as corneal dystrophy of Bowman layer type 2 (CDB2). Defects in TGFBI are the cause of Reis-Buecklers corneal dystrophy (CDRB) [MIM:608470]; also known as corneal dystrophy of Bowman layer type 1 (CDB1). Defects in TGFBI are the cause of lattice corneal dystrophy type 3A (CDL3A) [MIM:608471]. CDL3A clinically resembles to lattice corneal dystrophy type 3, but differs in that its age of onset is 70 to 90 years. It has an autosomal dominant inheritance pattern.
Defects in TGFBI are the cause of Avellino corneal dystrophy (ACD) [MIM:607541]. ACD could be considered a variant of granular dystrophy with a significant amyloidogenic tendency. Inheritance is autosomal dominant.
相似性
Contains 1 EMI domain.
Contains 4 FAS1 domains.
Contains 4 FAS1 domains.
功能
Binds to type I, II, and IV collagens. This adhesion protein may play an important role in cell-collagen interactions. In cartilage, may be involved in endochondral bone formation.
标记抗体
暂无标记数据
同靶标产品
暂无同靶标产品
相关文献
提示: 发表研究结果有使用 bsm-54085R 时请让我们知道,以便我们可以引用参考文章。作为回馈,资料提供者将获得我们送上的小礼品。
暂无相关文献
常见问题
暂无常见问题